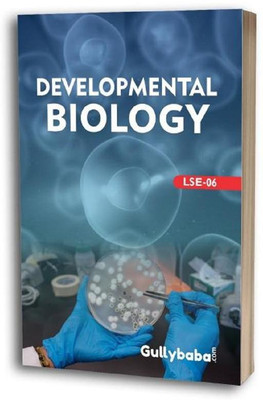

IGNOU LSE06 Developmental Biology In English Medium (Paperback, Shailja Saxena, Manju Srivastava)(Paperback, Shailja Saxena, Manju Srivastava)
Quick Overview
Product Price Comparison
LSE-06 Developmental BiologyCONTENTS COVEREDBlock-1 Plant Development-IUnit-1 Anther and OvuleUnit-2 GametogenesisUnit-3 Pollination and FertilisationUnit-4 EndospermUnit-5 EmbryogenesisUnit-6 Seed and FruitBlock-2 Plant Development-IIUnit-7 Root and Shoot MorphogenesisUnit-8 Effect of Plant Growth Regulators on DevelopmentUnit-9 Apical DominanceUnit-10 Secondary GrowthUnit-11 Plant Tissue and Organ CultureUnit-12 Current Trends in Developmental StudiesBlock-3 Animal Development-IUnit-13 Beginning of a New OrganismUnit-14 Cleavage and GastrulationUnit-15 Morphogenesis and Tissue OrganisationUnit-16 Mechanisms of Cell InteractionUnit-17 Organogenesis of Eye and LimbBlock-4 Animal Development-IIUnit-18 MetamorphosisUnit-19 RegenerationUnit-20 Growth, Aging, CancerUnit-21 Human Development QUESTION PAPERS1. Solution Paper - Dec 20142. Solution Paper - June 20153. Solution Paper - Dec 20154. Solution Paper - June 20165. Solution Paper - Dec 20166. Solution Paper - June 20177. Solution Paper - Dec 20178. Solution Paper - June 20189. Question Paper - Dec 201810. Solution Paper - June 2019